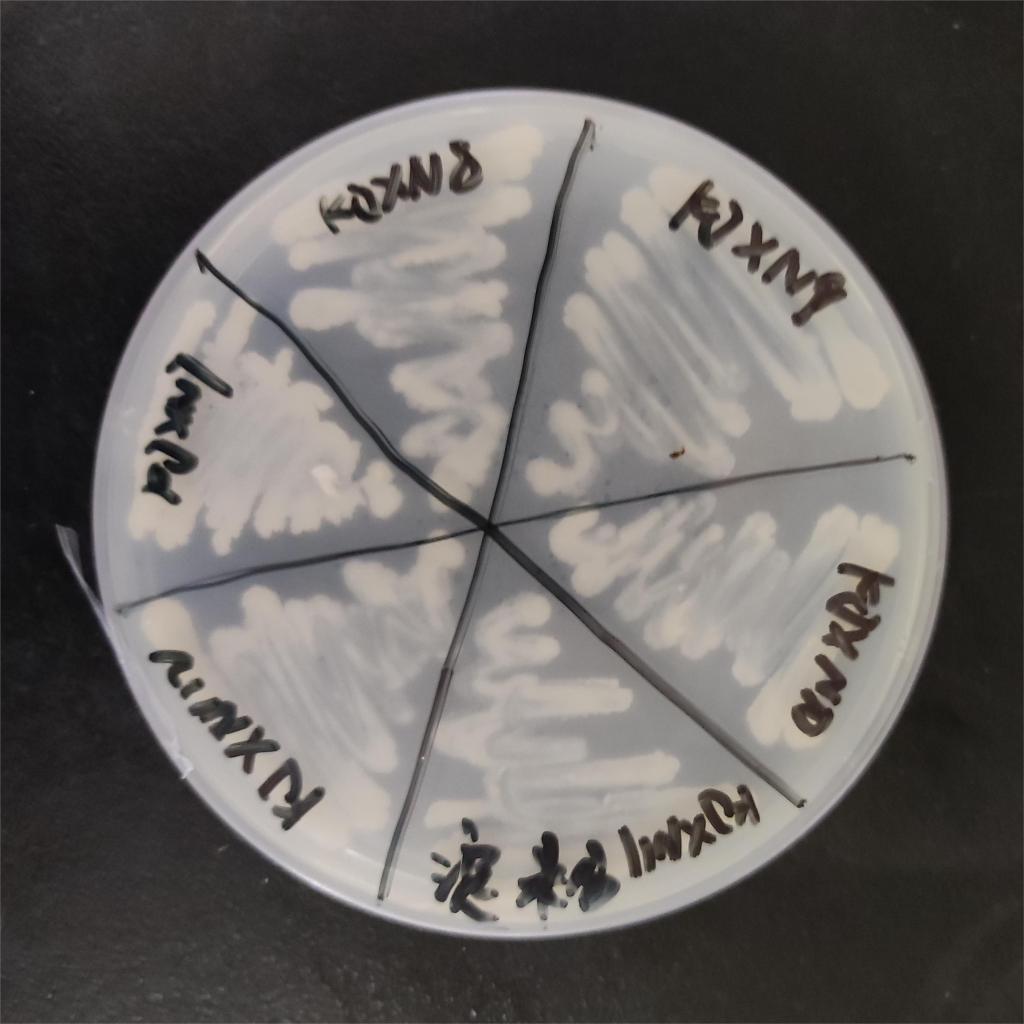

“这个蘑菇是用铁锅做的吗?可真有意思!”一进入村子,必一运动社区实践团的成员们,就被村里别出心裁的“装饰”所吸引。除了铁锅“绘”蘑菇,车轮栅栏、车轮垃圾桶等变废为宝的实例也随处可见。


10月的第一个清晨,由B-Sports微生物环境治理课题组员工组成的实践团队,走进杭州市淳安县,他们聚焦农村生活垃圾处理模式,希望探索出厨余垃圾与资源化设备组合的“运算法则”。
据了解,淳安县石林镇双西村、临岐镇仰韩村和范村村、千岛湖镇淡竹村在年初被列入省农业农村厅省级高标准农村生活垃圾分类示范村名单,因此成为了实践团队的切入点。“在这里,垃圾完成‘前半生’的任务后,进入另一个轮回,被赋予了新的使命。”实践团带队老师介绍。
通过过观察和调研,团队成员发现,农户每日产生的垃圾会由专门的垃圾运输车定时上门运往当地生活垃圾资源化处理站。当地处理站主要应用微生物优势菌种产生分解酶对厨余垃圾进行降解的技术,产出可利用的有机肥。成肥可用于售卖或农户自用,既是“取之于民,用之于民”的良好体现,又为村里带来了一定的收益。
与此同时,为激发农户参与垃圾分类的热情,村里制定了生态环保积分兑换制度。农户根据每月执行情况,利用获得的积分在兑换超市换取洗衣粉、肥皂、油、盐等生活日用品物品。“村里的年轻人外出打工,在家务农的老人赶集不方便,用积分兑换的日用品可以满足一些日常需求。”不少农户谈到这个制度,脸上都露出了满意的微笑。


经过总结,团队成员发现认为,厨余垃圾“+”资源化设备的结果远远“>”避免了资源浪费以及提升了农村环境舒适度,从经济角度来说,这种垃圾处理模式也具有长久的可行性。据悉,浙江省已有五百余个行政村作为试点,该垃圾处理模式或将在全省普遍推行。